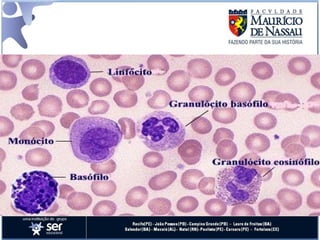

O documento descreve as características gerais do tecido conjuntivo, incluindo suas células e matriz extracelular. Apresenta os principais tipos de fibras e células encontradas no tecido conjuntivo frouxo, como fibroblastos, fibrócitos, macrófagos e mastócitos. Também diferencia os tipos de tecido conjuntivo como frouxo, denso, adiposo, cartilaginoso e ósseo.